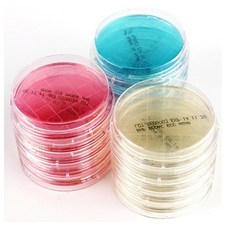
진균배지

진균배지 구매평모음 단점/장점 비용 선택 구입 노하우
IT 블로거 이만보 인사드립니다^^
오늘 포스팅에서는
진균배지에 관해 분석해볼께요.
【진균배지 HIT아이템 간단 리뷰정리】
< 블로그 내용 >
① 인터넷기사 ② 핵심영상 ③ 대박순위
☞ 진균배지 관련 주간 기사 정보 ☜
누에분말 진균배지, 값도 싸고 배양효율도 좋아
메디벳 ˝DTM 한계 극복한 새로운 피부사상균 진단 배지 출시˝
“배양효율 좋은 누에분말배지 기술이전 받아가세요”
☞ 관련 영상 ☜
☞ 랭킹순위 리스트 ☜
|
1위 미생물배지 PDA (Potato Dextrose Agar) – BD 213400 / 진균배양배지
97,900원 |
|
2위 생배지 PDA(Potato Dextrose Agar) 진균 효모/곰팡이 배양배지 50plates
113,300원 |
|
3위 [MEDION]메디온 식품공전 효모/진균/곰팡이 생배지 Potato Dextrose Agar(PDA) 20plate
37,500원 |
|
4위 3M 효모곰팡이(YM) 페트리필름 배양지
73,400원 |
|
5위 3M 대리점 페트리필름 속성효모곰팡이(RYM)
49,500원 |
|
6위 PDA(Potato Dextrose Agar) 진균 곰팡이 배양배지 NCM0018A BF-255 감자배지
43,500원 |
|
7위 진균 곰팡이 배양배지 [Difco-USA] Sorbit PDA(Potato Dextrose Agar) 500g BF-357
125,000원 |
|
8위 진균 곰팡이 배양배지 [HKM] PDA(Potato Dextrose Agar) 500g BF-374
69,500원 |
|
9위 보틀형 225ml 감마 멸균 희석액 생리 식염수 식품 미생물 대장균 시험 안전 검사 실험 기관 0.08 테스트 황색포도상구균 유산균 배지 분석 대장균군 진균 일반 세균 배양 스토마커
6,890원 |
|
10위 [MBCELL] PDB (Potato Dextrose Broth) (500g/5kg), Potato Dextrose Broth – 5kg
701,000원 |
|
11위 미생물배지 SDA (Sabouraud Dextrose Agar) – BD 210950 / 진균배양배지, SDA 500g – BD 210950
100,100원 |
|
12위 [생배지]PDA 진균실험배지 (1plate)BF-392 곰팡이균실험배지(개별포장)
3,950원 |
|
13위 [MEDION]메디온 식품공전 효모/진균/곰팡이 생배지 Potato Dextrose Agar(PDA) 50plate
78,900원 |
|
14위 보틀형 90ml 감마 멸균 희석액 생리 식염수 10개 식품 미생물 대장균 시험 안전 검사 실험 기관 0.08 테스트 황색포도상구균 유산균 배지 분석 대장균군 진균 일반 세균 배양 스토마커
18,330원 |
|
15위 진균 곰팡이 배양배지 [NEOGEN]SorbitPDA(Potato Dextrose Agar) 500g BF-310 NCM0018A
119,000원 |
|
16위 보틀형 1L 감마 멸균 희석액 생리 식염수 10개 식품 미생물 대장균 시험 안전 검사 실험 기관 0.08 테스트 황색포도상구균 유산균 배지 분석 대장균군 진균 일반 세균 배양 스토마커
16,810원 |
|
17위 SDA plate 효모 진균 배양용 배지 미생물 배지 sabouraud dextrose agar 생배지 (10 plates)
66,000원 |
|
18위 [MBCELL] PDA (Potato Dextrose Agar) – 500g/5kg, Potato Dextrose Agar-500g
125,000원 |
|
19위 표면의 균검사 [생배지] 로닥플레이트-진균(SDA) (1plate)BF-397 표면세균검사
3,950원 |
|
20위 YM (진균필름) MC-Media Pad (25ea/pk) (98865)
45,000원 |
인플루언서들이 추천할 만한 진균배지 상품들을 한눈에 보이게 리스트업해보았습니다.
제품정보, 가격 등은 항상 변동이 될 수 있다는 점 꼭 참고하시구요.
앞으로도 좋은 제품을 공유하기 위해 노력하겠습니다.
행운이 가득한 하루 보내세요~^^

위의 글은 광고제휴일환으로 일정액의 커미션을 받을수 있음 .